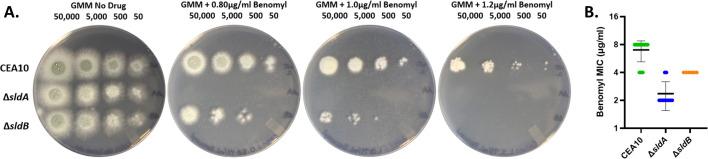
https://cdn.ncbi.nlm.nih.gov/pmc/blobs/8c5a/12323316/c1cdcf329907/spectrum.00536-25.f003.jpg

纺锤体组装检查点组件SldA或SldB的缺失会产生三唑异质抗性分生孢子群体。
Loss of the spindle assembly checkpoint components, SldA or SldB, generates triazole heteroresistant conidial populations.
作者信息
Nywening Ashley V, Thorn Harrison I, Xie Jinhong, Martin-Vicente Adela, Guruceaga Xabier, Ge Wenbo, Gibbons John G, Fortwendel Jarrod R
机构信息
Department of Clinical Pharmacy and Translational Science, College of Pharmacy, University of Tennessee Health Science Center, Memphis, Tennessee, USA.
College of Graduate Health Sciences, Integrated Biomedical Sciences Program, University of Tennessee Health Science Center, Memphis, Tennessee, USA.
出版信息
Microbiol Spectr. 2025 Aug 5;13(8):e0053625. doi: 10.1128/spectrum.00536-25. Epub 2025 Jun 16.
The opportunistic pathogen is the chief causative agent of human invasive filamentous fungal infections. Triazoles, the primary therapeutic options to combat invasive aspergillosis (IA), target the biosynthesis of ergosterol, a vital component of the fungal cell membrane. Unfortunately, resistance to this class of medical therapeutics has arisen globally and now threatens the future usefulness of these compounds for antifungal treatment. Infection with with acquired triazole resistance increases an already high associated mortality rate and reduces the limited arsenal of therapeutic options to combat IA. How this specific fungal pathogen obtains resistance remains poorly understood. In this study, we show that loss of the previously uncharacterized spindle assembly checkpoint (SAC) components, SldA or SldB, resulted in a heteroresistance phenotype to multiple mold active medical triazoles and to compounds inhibiting ergosterol biosynthesis at points upstream of the triazole target, Cyp51A. Consistent with conserved roles in mitotic fidelity, loss of either component resulted in the production of conidia characterized by an increased genome size, suggestive of potential aneuploidy development. Interestingly, we find that heteroresistance of the ∆ or ∆ conidial populations was only evident in response to ergosterol biosynthesis pathway inhibition and not seen with other external stress. Our findings support the hypothesis that specific links exist between SAC function and resistance to ergosterol biosynthesis perturbation in .IMPORTANCEThe rising threat of antifungal resistance in , a filamentous fungal species which remains one of the leading causes of human invasive infections, is an increasingly relevant concern to public health worldwide. The mode and mechanism of triazole resistance acquisition remain an understudied issue for this opportunistic pathogen. This work uncovers a novel role for a functional spindle assembly checkpoint in maintaining susceptibility to ergosterol biosynthesis inhibitors, including the triazole antifungal drug class.
这种机会致病菌是人类侵袭性丝状真菌感染的主要病原体。三唑类药物是对抗侵袭性曲霉病(IA)的主要治疗选择,其作用靶点是麦角甾醇的生物合成,麦角甾醇是真菌细胞膜的重要组成部分。不幸的是,全球范围内已出现对这类药物的耐药性,这一情况正威胁着这些化合物在抗真菌治疗中的未来应用价值。感染获得性三唑耐药性的该病原体,会使原本就很高的相关死亡率进一步增加,并减少对抗IA的有限治疗手段。目前对于这种特定真菌病原体如何获得耐药性仍知之甚少。在本研究中,我们发现,之前未被鉴定的纺锤体组装检查点(SAC)组分SldA或SldB缺失,会导致对多种霉菌活性的医用三唑类药物以及在三唑靶点Cyp51A上游位点抑制麦角甾醇生物合成的化合物产生异质性耐药表型。与在有丝分裂保真度方面的保守作用一致,任一成分缺失都会导致分生孢子的产生,其特征是基因组大小增加,提示可能发生了非整倍体发育。有趣的是,我们发现ΔsldA或ΔsldB分生孢子群体的异质性耐药仅在麦角甾醇生物合成途径受到抑制时才明显,在其他外部应激条件下则未观察到。我们的研究结果支持这样一种假设,即SAC功能与该病原体对麦角甾醇生物合成干扰的耐药性之间存在特定联系。
重要性
在人类侵袭性感染的主要病因之一的丝状真菌物种中,抗真菌耐药性的威胁日益增加,这是全球公共卫生领域日益关注的问题。对于这种机会致病菌,三唑耐药性的获得方式和机制仍是一个研究不足的问题。这项工作揭示了功能性纺锤体组装检查点在维持对麦角甾醇生物合成抑制剂(包括三唑类抗真菌药物)敏感性方面的新作用。